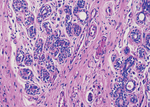

You have no items in your shopping cart.
Note:It is mainly used for staining the cytoplasm.
Model & Specification
| Catalog# | Model | Description | Pack Size |
| 4960211 | Alcohol-soluble | Alcoholic solution of Eosin | 500mL/bottle |
| 4960221 | Water-soluble | Aqueous solution of Eosin | 500mL/bottle |
Introduction
The nucleus in the cell has a certain degree of acidity, and it has a strong affinity with the basic stain (hematoxylin), while the cytoplasm is on the contrary, which has a certain degree of basicity and a strong affinity with the acid stain (eosin). After cell smears or tissue sections are subject to hematoxylin-eosin staining, the nucleus will be stained blue-purple by hematoxylin, cytoplasm, muscle fibers, collagen fibers, etc. will be red in varying degrees, and red blood cells will be orange-red.


Main Compositions
Eosin, Ethanol, Acetic acid
Sample Requirement
Smears and sections must be fully fixed, and paraffin sections must be fully deparaffinized.
Procedures
-
Deparaffinize the sections for 5-10 min in xylene I, II and III respectively, and then transfer into 100% and 95% ethanol respectively for 1-3 min each;
-
Immerse in 85% ethanol for 1-3 min and rinse with tap water for rehydration for 1-3 min;
-
Stain in Hematoxylin Staining Solution for 3-5 min, and rinse with tap water for 1-2 min;
-
Differentiate in Differentiation Solution for 1-10 sec; and rinse with tap water for 2min;
-
Bluing with running water for 5-10 min; or bluing with bluing solution for 1-3 min then rinse with tap water for 1-3 min;
-
Immerse in Eosin Staining Solution (Water-soluble) for 30-60 sec; or dehydrate in 85% ethanol, then stain in Eosin Staining Solution (Alcohol-soluble) for 10-30 sec (Water washing should be avoided);
-
Adjust color for 2 min in 95% ethanol I and II respectively;
-
Dehydrate for 1-3 min through 100% ethanol I and II respectively, and clear in xylene I and II for 1-3 min respectively;
-
Mount with mounting medium and coverslips, observe the result under microscope.
Materials Required But Not Provided
Appropriate material is required for immunohistochemical (IHC) staining protocol, such as graded alcohols, xylene or xylene substitutes, hematoxylin staining solution, differentiation solution, bluing solution, etc.
Interpretation of Test Results
Nuclei show blue purple. Cytoplasm, intercellular substance and fibrin show pink to red. And the red cells would show orange red.
Precautions
-
For professional use only;
-
The user shall operate in strict accordance with the instructions; Work clothes, gloves and masks shall be wore when operating, and the operating environment shall be ventilated as possible.
-
The prepared smears or sections shall be fully fixed. Paraffin sections shall be fully deparaffinized, otherwise non-staining or uneven staining will be caused.
-
The Differentiation Solution shall not be used for too long. The smear or section should be washed with clear water immediately when it turn pink.
-
The differentiation time shall not be too long, and the smears or sections shall be rinsed with clear water immediately after they turn pink.
-
Staining time can be properly shorten in summer or at higher temperature, and it can be properly prolonged in winter or at lower temperature.
-
After staining with Eosin, should not wash with ethanol for too long, otherwise it would cause decolorization of eosin.
-
Change the gradient ethanol regularly to ensure the purity.
-
This staining solution is for in vitro diagnostic (IVD) use only and it needs to be used within the validity.
-
Dispose of all containers, waste liquid and slides in accordance with national regulations, including unused items and used items.
Limitations
Only for staining of cell morphology and histomorphology observation. The staining time and staining quality are affected by temperature, season, operator's experience, sample preparation and section quality.
Disposal
Waste must be disposed of in compliance with local legislation. Take the appropriate precautions for infected material if necessary.
Storage Conditions and Expiry Date
Storage at 10℃-30℃, valid for 12 months.
Document
Brochure for Staining Solution
When can I expect my order to ship?
Most orders are filled and shipped within 2-3 business days from the time they are received.
Our standard shipping usually take 2-5 days.
We also provide express shippping for time-sensitive deliveries.
Email contact@biofargo.com if you have any requirements.